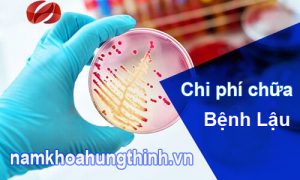
chi phí chữa bệnh lậu hết bao nhiêu tiền

Chuyên khoa
Bệnh lậu

Nguyên nhân triệu chứng và cách điều trị bệnh lậu ở nam giới
“ Chào bác sĩ, Gần đây “ cậu nhỏ ” của tôi bị đau buốt, đau là khi cương cứng, quan hệ hay xuất tinh thường cảm thấy đau buốt nhiều khi còn xuất tinh ra máu. Qua tìm...

Bệnh lậu ở nữ giới – Nguyên nhân, dấu hiệu và cách điều trị
Bệnh lậu là một căn bệnh xã hội nguy hiểm ở cả nam và nữ. Tuy nhiên đối với bệnh lậu ở nữ giới, khi lậu cầu khuẩn mới xâm nhập vào cơ thể chưa có những biểu hiện...

Hình ảnh bệnh lậu ở miệng, họng, lưỡi ở nam và nữ giới
Hình ảnh bệnh lậu sẽ giúp người bệnh bước đầu hình dung được sự nguy hiểm và mức độ tàn phá của nó đối với cơ thể. Bệnh lậu không chỉ bị ở bộ phận sinh dục mà nó...

Bệnh Lậu Ở Miệng Nguyên nhân, Triệu Chứng Và Lây Qua Đâu?
Bệnh lậu từ lâu vốn đã được biết đến là một căn bệnh lây truyền qua đường tình dục tuy nhiên nhiều trường hợp bệnh lậu phát triển ở miệng khiến cho người bệnh vô cùng lo lắng và...

Bệnh lậu kiêng ăn những gì?
Bệnh lậu nên kiêng ăn những gì? Chắc hẳn đây là thắc mắc chung của nhiều người khi vô tình nhiễm phải lậu khuẩn và cần phải tìm phương hướng điều trị tích cực nhanh chóng, trong đó thói...

Bệnh lậu – nguyên nhân, triệu chứng và cách chữa
Bệnh lậu là gì? là điều mà nhiều người muốn biết. Nhiều trường hợp không biết rõ nguyên nhân gây bệnh lậu như thế nào? triệu chứng của bệnh lậu ở nam và nữ giới ra sao? có giống...

Địa chỉ chữa bệnh lậu ở đâu Hà Nội chất lượng tốt?
Tâm sự của nhiều nam giới về nỗi băn khoăn không biết nên khám bệnh lậu ở đâu cũng như chữa bệnh lậu ở đâu tốt tại Hà Nội qua một cuộc khảo sát. Anh T – Ở Hoàng...

Hướng dẫn sử dụng thuốc chữa bệnh lậu hiệu quả
Virus gây bệnh lậu là một trong những loại mầm bệnh vô cùng nguy hiểm vì khó phát hiện, khó tiêu diệt và dễ dẫn đến các biến chứng nghiêm trọng cho sức khỏe, tính mạng người bệnh. Nhiều...
Mức chi phí chữa bệnh lậu hết bao nhiêu tiền?
Chữa bệnh lậu hết bao nhiêu tiền? Năm 2019 người bệnh rất quan tâm đến mức chi phí chữa bệnh lậu. Và thông thường xoay quanh vấn đề giá tiền chữa bệnh lậu có rất nhiều những băn khoăn,...

Bệnh lậu có chữa khỏi được không?
Bệnh lậu là một căn bệnh xã hội vô cùng nguy hiểm do song cầu khuẩn lậu Neisseria Gonorrhoeae gây ra. Bệnh lậu gây nên nhiều hệ lụy nguy hiểm đến sức khỏe và tâm lý của người bệnh...

Thắc mắc hỏi ngay - lâu ngày khó chữa
Giúp bạn bảo vệ sức khoẻ trọn đời









Bình luận